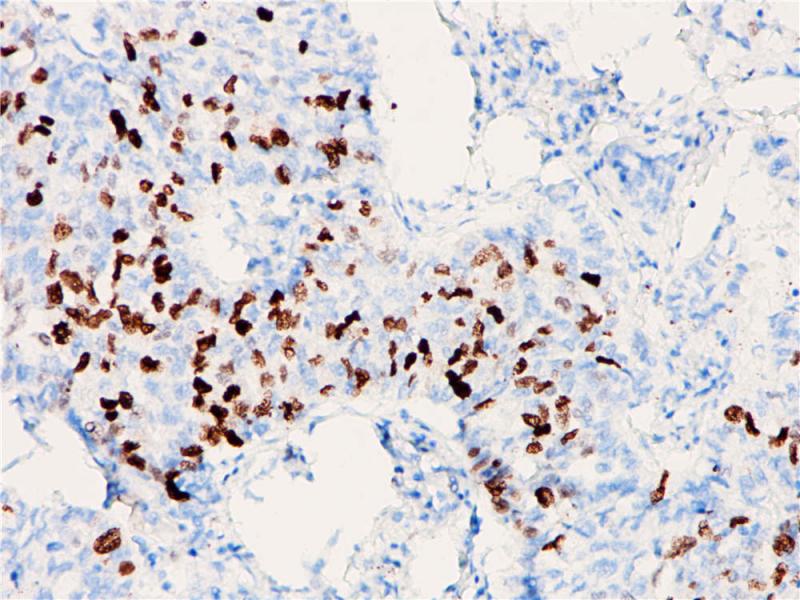
肺癌 Topoisomerase Ⅱ-α (BP6016) 染色

产品中心

宫颈癌 Topoisomerase Ⅱ-α (BP6016) 染色
肺癌 Topoisomerase Ⅱ-α (BP6016) 染色
Topoisomerase II-α 重组兔单克隆抗体
Thyroglobulin(TG)是一种在甲状腺特异性表达的二聚体糖蛋白,属于B型羧酸酯酶家族。它是甲状腺激素T3与T4的前体。TG的变化通常与3型自身免疫性甲状腺疾病相关。TG合成缺陷通常会导致先天性甲状腺功能低下。甲状腺中TG的缺失和碘清蛋白浓度的上升,最终导致T3和T4的合成障碍。甲状腺球蛋白在正常甲状腺组织以及分化的甲状腺癌细胞中表达。这个指标常用来鉴别甲状腺来源的肿瘤。
Specifications
- 目录号
- BX50011
- 克隆号
- BP6016
- 阳性对照
- 宫颈癌
- 亚细胞定位
- 细胞核
- 组织类型
- FFPE
- 修复方式
- HIER
- 稀释比
- 1:100-1:200
- 规格
- 100μl/vial, 1ml/vial
- 用途
- RUO
Reference
1.Lynch BJ, et al, Hum Pathol. 1997 Oct;28(10):1180-8
2.Gupta D, et al, Appl Immunohistochem Mol Morphol. 2001 Sep;9(3):215-21.


